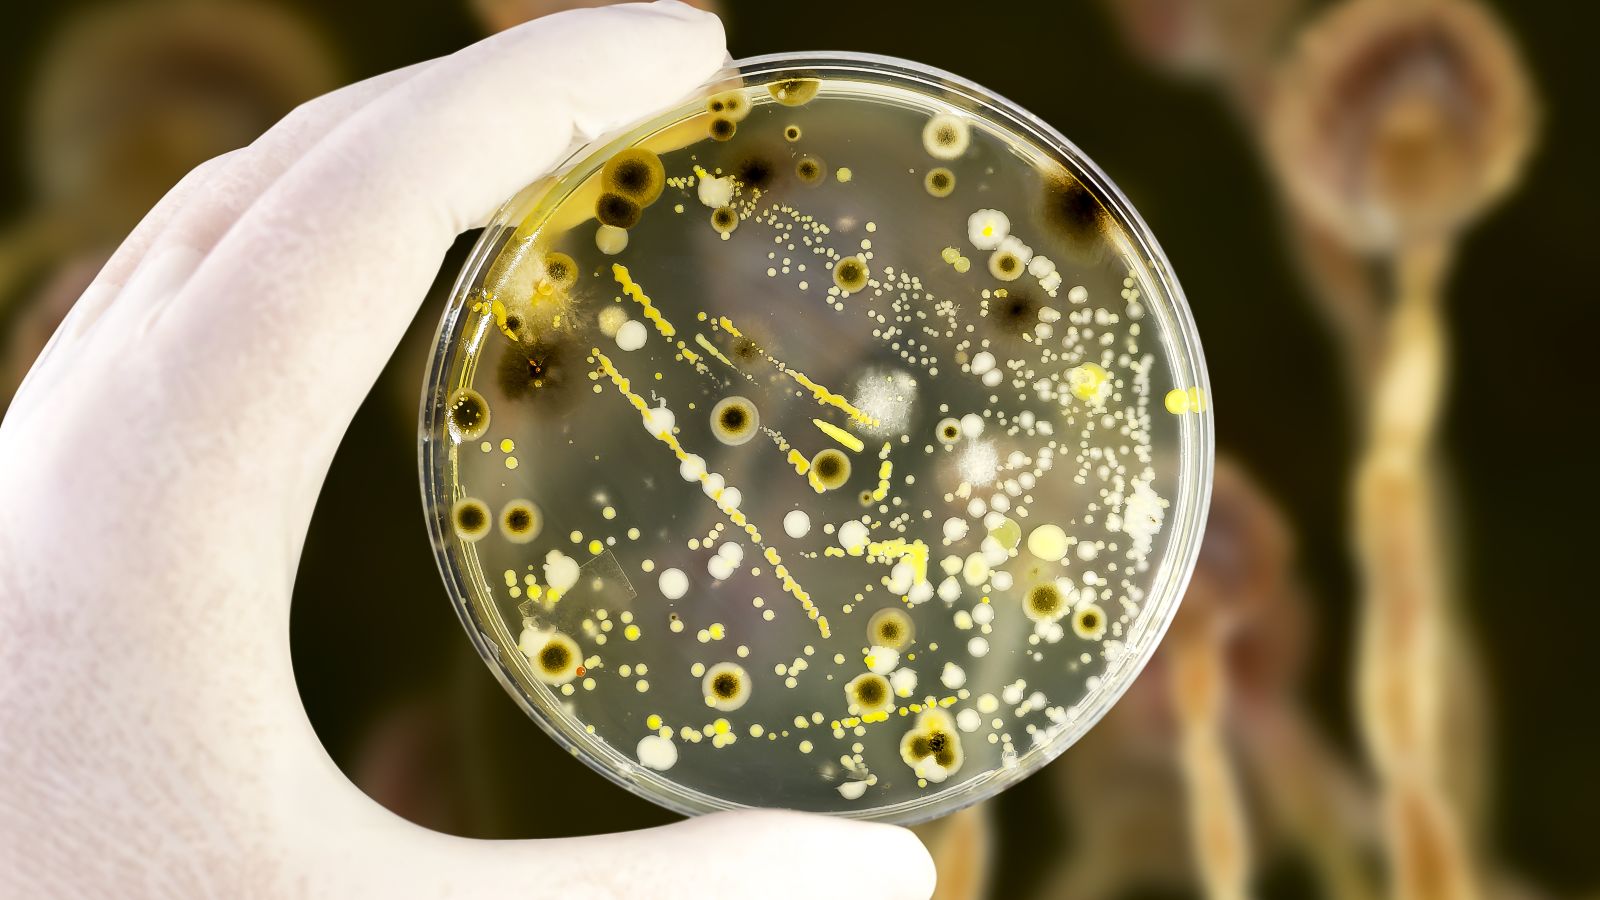

23.05.2025 Bioökonomie, Circular Economy, Horizont Europa
Sondierung zur geplanten Biotech-Verordnung
Die EU-Kommission startet eine Sondierung zur geplanten Biotech-Verordnung, um Europa als Innovationsstandort für Biotechnologie zu stärken – mit klaren Fristen und Beteiligungsmöglichkeiten für Forschung und Wirtschaft.
Mit dem geplanten „European Biotech Act“ will die EU-Kommission neue Impulse für die Biotechnologie in Europa setzen. Ziel ist es, die regulatorischen und finanziellen Rahmenbedingungen entlang der gesamten Innovationskette – von der Grundlagenforschung bis zum Markteintritt – deutlich zu verbessern. Dabei sollen höchste Sicherheitsstandards für Umwelt und Bevölkerung gewährleistet bleiben.
Im Zentrum der aktuellen Sondierung stehen zentrale Herausforderungen für die europäische Biotechnologie- und Bioproduktionslandschaft. Die Kommission bittet Akteure aus Wissenschaft, Wirtschaft und Gesellschaft um Stellungnahmen zu möglichen Erleichterungen bei Entwicklung, Zulassung und Verbreitung biotechnologischer Produkte sowie zu deren wirtschaftlichen, sozialen und ökologischen Auswirkungen. Rückmeldungen sind bis zum 11. Juni 2025 über diese Webseite der EU-Kommissionmöglich.
Parallel hat die EU eine Ausschreibung für eine Studie gestartet, die konkrete Maßnahmen zur Förderung von Innovation und Wettbewerbsfähigkeit im Biotech-Sektor analysieren soll. Die Ergebnisse sollen in den Gesetzesvorschlag einfließen, der für das dritte Quartal 2026 angekündigt ist. Angebote für die Studie können bis zum 26. Juni 2025 eingereicht werden.
Weitere Informationen zur Ausschreibung finden Sie im EU Funding & Tenders Portal.